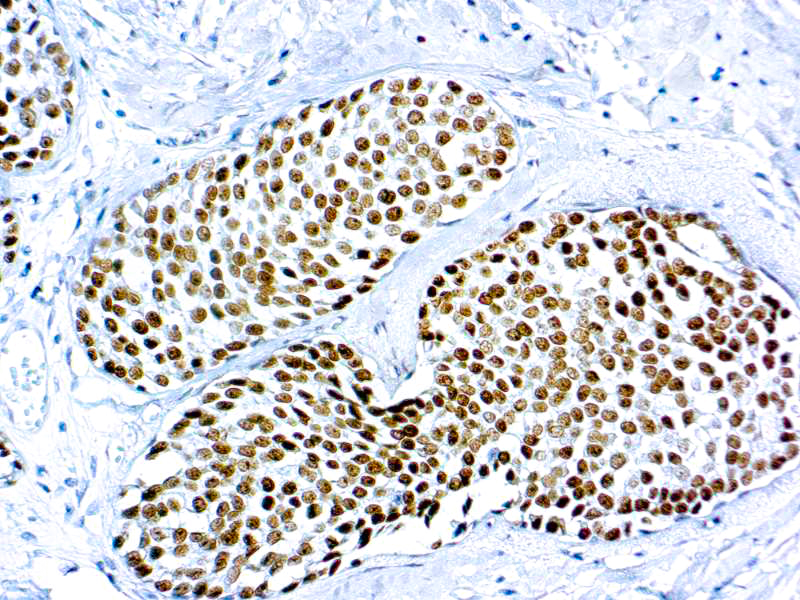

GATA3 (L50-823)
Description
GATA3 binding protein 3 or GATA3, is a zinc finger transcription factor and plays an important role in promoting and directing cell proliferation, development, and differentiation in many tissues and cell types. The human GATA3 gene has been mapped to chromosome 10p15. GATA =3 expression is primarily seen in breast carcinoma and urothelial carcinoma. Anti-GATA3 can also be useful in the identification of unknown primary carcinoma when carcinomas of the breast or bladder are a possibility
Additional information
| Clone | L50-823 |
|---|---|
| Isotype | IgG1 |
| Immunogen | Peptide between trans-activation and DNA-binding domains of GATA-3 |
| Species | Mouse |
| Cellular Localization | Nuclear |
| Positive Control Tissue | Breast carcinoma, Urothelial Carcinomas |
| Pretreatment | EDTA Buffer pH8.0 |
| Incubation & Temperature | 30 min @ RT |
| Intended Use | IVD |
| Detection System | PolyVue Plus – Two Step Detection System or Montage PolyVue Plus Auto Detection System for Montage 360 System |
| Description/Type | Mouse Monoclonal Antibody |
| Format | This product is supplied as a purified immunoglobulin and contains sodium azide as a preservative. |
DATASHEETS & SDS
DATASHEETS & SDS
| Download Datasheet |
| Download SDS Sheet – OSHA |
REFERENCES
REFERENCES
- Higgins JP, et al. Am J Surg Pathol. 2007; 31:673-680
- Liu H, et al. Am J Clin Pathol. 2012; 138:57-64
- Joulin V, et al. EMBO J 1991; 10:1809-16
- Labastie M, et al. Genomics; 21:1-6
Reviews (0)
Only logged in customers who have purchased this product may leave a review.

Reviews
There are no reviews yet.